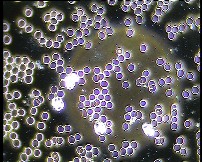
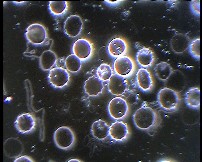

Praxis für klassische Homoeopathie
Hauptmenü
Dunkelfelddiagnostik
Behandlung
Die Dunkelfelddiagnostik oder Dunkelfeldmikroskopie des Blutes zählt zu den alternativen ganzheitlichen Diagnoseverfahren. Die Methode wurde in den Zwanziger Jahren von Prof. Dr. Günther Enderlein entwickelt.
Ein kleiner Tropfen Blut aus der Fingerbeere oder dem Ohrläppchen wird sofort unter dem Dunkelfeldmikroskop betrachtet und im Beisein des Patienten können erste Beurteilungen gemacht werden.
Für eine ausführliche Diagnostik ist eine Beobachtung des Blutes über mehrere Stunden notwendig.
Bei der konventionellen Laboruntersuchung wird die Anzahl der Blutzellen, der Blutfettwerte, u.ä. gemessen.
Bei der Dunkelfelddiagnostik beurteilt man vor allem die Qualität der Blutkörperchen, also deren Funktionstüchtigkeit und deren Umgebung, das sogenannte Milieu.
Durch Anwendung dieses Verfahrens lassen sich Erkrankungstendenzen, Übersäuerung und chronische Krankheiten bis hin zu Krebs schon im Frühstadium erkennen. Die aktuelle Stoffwechsellage und die Immunitätslage wird beurteilt, man kann Hinweise auf Organbelastungen, Allergien, Pilzerkrankungen u.a. sehen.
Für eine gute Beurteilung der Ergebnisse der Dunkelfelddiagnostik ist das Wissen um die Beschwerden des Patienten und seine Krankengeschichte notwenig.
Da frühzeitig Erkrankungstendenzen beobachtet werden können, eignet sich diese Methode sehr gut zur Vorsorge. So können rechtzeitig Änderungen in den Lebensgewohnheiten, der Ernährung usw. vorgenommen werden oder wenn nötig auch therapeutische Schritte eingeleitet werden.
Auch zur Therapiekontrolle ist die Dunkelfelddiagnostik von großem Wert.

Untermenü
- Gesundheits-Check-up
- Homöopathische Behandlung
- Ernährungsberatung
- Dunkelfelddiagnostik ←
- PEP
- Akute Behandlung